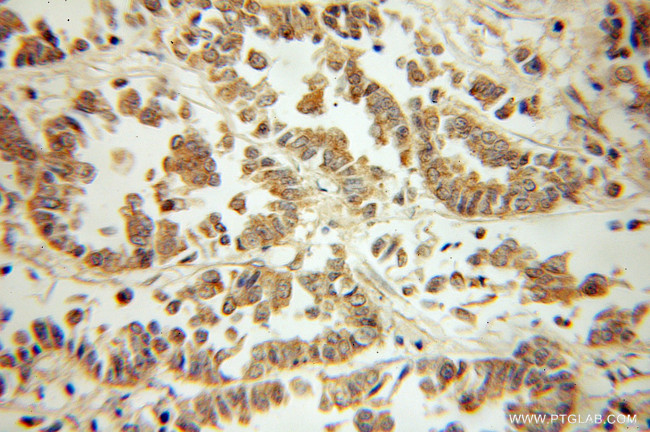
Phospho-ZIPK (Ser311) Antibody in Immunohistochemistry (Paraffin) (IHC (P))

Search
Proteintech
Phospho-ZIPK (Ser311) Polyclonal Antibody
{{$productOrderCtrl.translations['antibody.pdp.commerceCard.promotion.promotions']}}
{{$productOrderCtrl.translations['antibody.pdp.commerceCard.promotion.viewpromo']}}
{{$productOrderCtrl.translations['antibody.pdp.commerceCard.promotion.promocode']}}: {{promo.promoCode}} {{promo.promoTitle}} {{promo.promoDescription}}. {{$productOrderCtrl.translations['antibody.pdp.commerceCard.promotion.learnmore']}}
产品信息
51021-1-AP
已发表种属
宿主/亚型
分类
类型
抗原
偶联物
形式
浓度
保存条件
运输条件
产品详细信息
This antibody is specific to ZIPK-Phospho 311Ser.
靶标信息
DAPK3 is a serine/threonine kinase which is functionally linked to cell motility, smooth muscle contractility and cell death processes. DAPK3 is encoded by ZIPK and is a component of desmosomes and of the epidermal cornified envelope in keratinocytes. The N-terminal domain of this protein interacts with the plasma membrane and its C-terminus interacts with intermediate filaments. Through its rod domain, this protein forms complexes with envoplakin. This protein may serve as a link between the cornified envelope and desmosomes as well as intermediate filaments. AKT1/PKB, a protein kinase mediating a variety of cell growth and survival signaling processes, is reported to interact with this protein, suggesting a possible role for this protein as a localization signal in AKT1-mediated signaling.
仅用于科研。不用于诊断过程。未经明确授权不得转售。